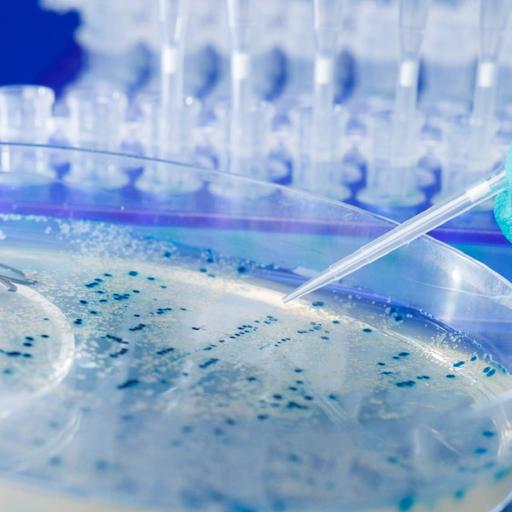

Heredity & Genetics
The passing on of traits from parents to their offspring is known as heredity; offspring cells or organisms acquire the genetic information of their parents through asexual or sexual reproduction. Variations between individuals can accumulate via inheritance, causing species to evolve through natural selection. Genetics is the study of heredity in biology. Genetics is the study of how heritable qualities are passed down from one generation to the next. Humans have long noticed that features in families tend to be similar. Genetics is one of biology's major pillars, and it intersects with a variety of other fields such as agriculture, medicine, and biotechnology. The discovery of genes, the fundamental components responsible for inheritance, gave rise to genetics. Genetics can be described as the study of genes at the molecular level.